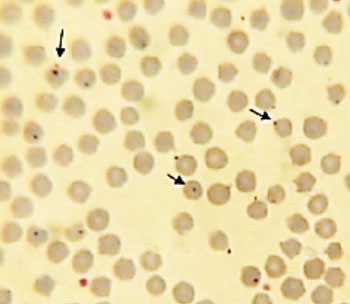
图片B：感染的绵羊血图片中的羊边虫（US National Institutes of Health）。

新的山羊病原体感染人类
By LabMedica International staff writers
Posted on 26 Jun 2015
在此前3周内有蜱虫暴露史的患者中,边虫病常与血小板减少症、白细胞减少和/或肝酶水平升高相关。Posted on 26 Jun 2015
如果未接受治疗,或在老年和免疫功能低下的患者中抗生素治疗的启动延迟,边虫病可能病情严重,甚至危及生命,但大多数患者的边虫病是轻度的,且病例致死率低。
北京微生物学和流行病学研究所(中国)从2014年5月1日至6月10日,从本地医院采集了之前两个月内有蜱虫叮咬史的患者的血液样品。为检测新的边虫物种,他们使用了套式聚合酶链反应(PCR)。他们将阳性样品接种于细胞培养物中,并通过形态学分析和种系发生分析确定了分离的病原体的特征。它们还通过间接免疫荧光法检测血清抗体。
根据PCR和测序,团队人员发现接受评估的477名患者中,28名(6%)感染了新的边虫物种。他们体外分离了三名患者的病原体。数种蛋白质基因合并系统发生分析,包括主要表面蛋白质-2(msp2)和msp4,显示病原体直接来自所有已知的边虫物种。所有阳性样品的核酸序列扩增彼此相同,并与山羊检测的相应序列相同。
大多数患者发生血清转化或抗体效价增加至4倍。全部28名患者发展成非特定性发热性表现,包括23名患者(82%)发热、14名患者(50%)头痛、13名患者(46%)出现疟疾,9名患者(32%)眩晕,4名患者(14%)肌痛,4名患者(14%)发生寒战。此外,28名患者中有10名(36%)有皮疹或焦痂,8名(29%)有淋巴结病,8名(29%)有胃肠道症状,3名(11%)有颈部僵硬。5名患者因为严重疾病住院。17名患者中有6名(35%)数据可用者肝转氨酶浓度高。
作者临时命名病此原体为“山羊属边虫”。绵羊和山羊中发现了相似的病原体边虫,但人类感染者者非常罕见。山羊属边虫的已知载体是硬蜱蜱虫。本研究已发表于2015年3月29日刊的Journal of Infectious Diseases(柳叶刀传染病杂志)。
Related Links:
北京微生物学和流行病学研究所